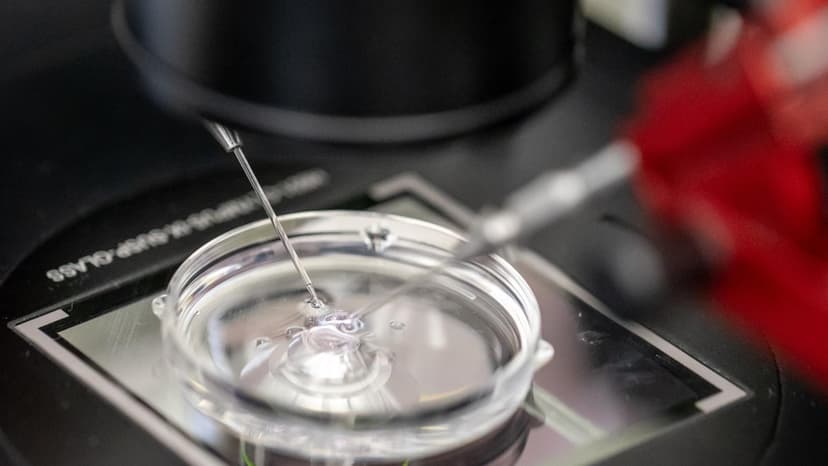
France Encourages Young Adults to Freeze Eggs and Sperm

Spanish President Sánchez's Surprise Interaction with Citizens
Spanish President Pedro Sánchez surprised a group of citizens visiting the Moncloa Palace by greeting them and joining their tour.
200 stories found
Spanish President Pedro Sánchez surprised a group of citizens visiting the Moncloa Palace by greeting them and joining their tour.

Portuguese deputies have welcomed the release of four Portuguese citizens – Carla da Silva Marrero, Pedro Fernández, Jaime dos Reis Macedo, and Manuel Enrique Ferreira – from detention in Venezuela. Parties are now calling for the release of five other Portuguese citizens who remain detained.
The American Central Intelligence Agency (CIA) has publicly posted instructions on its official X account, guiding Iranian citizens on how to securely contact the agency.

A Forsa survey for F.A.Z. indicates that Frankfurt's daily newspapers are the most important mass media source for citizens seeking information about local events, particularly for municipal elections.

The White House has issued a warning to Mexican drug cartels not to harm American citizens, stating they will 'pay dearly' if they do, following the reported death of Jalisco New Generation Cartel leader Nemesio Oseguera Cervantes.
For the past decade, Sunny Kaushal has been a man on a mission to crack down on retail crime, and he's one step closer to getting his way

Peter Obi has spoken out following an alleged assassination attempt, emphasizing the need to address terrorism and officials terrorizing citizens.

Smailović states that the issue is not about positions but about discrimination, which individuals can accept on their own behalf but not on behalf of the people or the citizens of Montenegro.

A Slavic studies professor in Lviv, Ukraine, describes teaching until air raid alerts are declared, then moving with students to shelters, highlighting how citizens have adapted to wartime life.

The Moldovan Embassy in Canada has advised its citizens to avoid non-essential travel to Mexico due to outbreaks of violence in various regions of the country.

The Albanese government is accused of a drastic change in rhetoric regarding its legal obligations to Australian women and children stranded in Syria, moving from compassion to contempt, signaling a shift in political strategy.

Greek Minister Kostis Hatzidakis announced ambitious targets for 2026, emphasizing continued strong economic growth and progress based on commitments to citizens.
The opposition PS movement in Slovakia warns of potential restrictions on voting from abroad, urging the government not to change the electoral law to the detriment of citizens living outside Slovakia.
New rules for entering the United Kingdom come into full effect on Wednesday, February 25, requiring an Electronic Travel Authorisation (ETA) for travelers, including Polish citizens.

British citizens are advised to avoid seven destinations by 2026 due to overtourism. While these locations may be appealing, it is recommended to refrain from traveling there for now.

Dorian Teliti, Deputy Mayor of Tirana City Council, denounced a scandal involving 'secret decisions against citizens' and the absence of a financial commission for 32 months, hindering the council's work.

Numerous citizens are facing issues due to a Ministry of Interior decision to indefinitely block scooter circulation, with increasing reports of police escorting minors without parents or psychologists, prompting calls for investigation into police brutality.
Uzbekistan’s Tax Committee has paid 3 billion Soums to citizens for reporting tax violations through the Soliq Hamkor System.
Approximately 200 citizens from Uzbekistan have commenced work on Türkiye’s Akkuyu Nuclear Power Plant project.

In its latest advisory, the Embassy of India asked its citizens to "leave Iran by available means of transport, including commercial flights."

The Free Citizens Movement (PSG) has filed a criminal complaint against the decision-makers who declared a facility in Vrčin suitable for storing hazardous pharmaceutical waste.

Chinese citizens traveled by train in record numbers during the recent New Year holidays, indicating a significant increase in holiday travel.
Citizens are reportedly pushing back against efforts to extend President Mnangagwa's term in office.
Taiwan has issued a warning to its citizens that those arrested for fraud overseas might be deported to China.

Technological advancements will allow Romanian citizens to obtain official documents, certificates, and authorizations online by 2026, significantly reducing bureaucratic complexity and time spent at physical counters.
An expert emphasizes that transparency is key for the state and citizens, raising questions about who drafts laws for Karol Nawrocki, especially concerning economic interests.

Slovenia has set a goal for at least half of its citizens to achieve higher education, with a recent display of enrollment status for a study program being deemed inaccurate and misleading.
Roger Martínez-Dávila says he was suddenly told to prove his US citizenship by the University of Colorado, where he’s been working for the last 16 years. It wasn’t required of his department colleague
Chubb (CB) is strengthening its growth in emerging markets through a partnership with Nubank, prompting Citizens to maintain a Market Outperform rating.

A bold reform vision for Venezuelan oil: strip the State of profit share, and make citizens the chief stakeholders and protectors of the industry
Robinhood Markets, Inc. to Present at the Citizens Technology Conference on March 2, 2026 The Globe and Mail

Former President Yoon Suk Yeol has been sentenced to life imprisonment in an insurrection trial, a verdict that has caused emotional dissonance among citizens.

The Croatian Judges' Association (UHS) warns that controversial transfers of Zadar judges without consent threaten judicial independence and citizens' right to a fair trial.

French prosecutors have requested prison sentences of up to three years for three Moldovan citizens who painted coffins on public buildings in Paris, referencing the war in Ukraine.
U2 has collaborated with Ukrainian artist Taras Topolia from the band Antytila on a project aimed at providing music therapy for Ukrainian citizens, emphasizing the importance of remembrance.

Sali Berisha denounced the Socialist Party for refusing to vote on SPAK's request to lift Deputy Prime Minister Belinda Balluku's immunity, calling for citizens to protest for Rama's arrest.
The Czech Republic recognizes the importance of supporting Ukraine, as demonstrated by citizens raising 7 billion Czech korunas for Ukraine since the start of the war.

The United Kingdom and the Federal Government of Nigeria have issued a joint warning to Nigerians, urging them to thoroughly verify overseas job offers due to the increasing risks of cyber-trafficking and exploitation.

Students from the 'Mihajlo Pupin' Technical Faculty in Zrenjanin have expressed support for farmers from Central Banat who announced road blockades for the following day, calling on citizens to join them.

On the fourth anniversary of the war, it is highlighted that support for Ukraine also serves as a way for Europeans to buy time, recalling that Ukrainian sovereignty was preserved by the massive courage of ordinary citizens in 2022.

The Delhi government announced a new initiative to reward individuals with Rs 25,000 for helping accident victims, aiming to encourage timely assistance.

Warning from Department of Foreign Affairs follows killing of wanted drug trafficker

The European Union has imposed sanctions on an additional eight Russian citizens, accusing them of severe human rights violations and undermining the rule of law in Russia.

Around 50 million US citizens live in the affected area of the approaching storm. Power outages are expected, and floods are also possible.
Kuwait has mandated military service for all male citizens upon reaching the age of 18.

MANILA, Philippines — Philippine National Police (PNP) chief Gen. Jose Melencio Nartatez Jr. urged the public to report the sale of illegal cigarettes retail outlets across the country. “As part of the nationwide crackdown, the PNP is calling on citizens to act as the ‘eyes and ears’ of the police,” Nartatez said in a statement

The Telangana Drug Control Administration (DCA) has initiated a public awareness campaign to educate citizens about antimicrobial resistance and promote responsible use of antibiotics.

Singapore's Coordinating Minister for National Security K Shanmugam announced that the country will take action against citizens who fight overseas in foreign causes, emphasizing the importance of racial and religious harmony.
Three Polish citizens, wanted on arrest warrants, were apprehended directly at airports upon their return to Poland and immediately transferred to correctional facilities.
Why are traditional media necessary for every society and what is the situation in countries where citizens are reduced to information from the internet? What about

Italian President Sergio Mattarella visited Niscemi, a Sicilian town recently affected by a landslide, where he was welcomed by citizens.

Bulgaria's Constitutional and Legal Affairs Committee will discuss President Iliana Yotova's veto against the Electoral Code. The President returned the amendments, which restrict voting sections for citizens in non-EU countries, for reconsideration.
India tells citizens to leave Iran The Daily Star

India's Ministry of External Affairs has urged its citizens to leave Iran as Washington increases military pressure on Tehran.
India tells citizens to leave Iran: embassy Arab News
Sweden's government plans to significantly tighten requirements for Swedish citizenship, including for those who have already applied. The Council on Legislation has strongly criticized this proposal.

School was canceled in several Mexican states and local and foreign governments alike warned their citizens to stay inside, as widespread violence erupted following the army's killing of the powerful leader of the Jalisco New Generation Cartel.

Citizens in Belgrade gathered again near Ušće Park to protest the planned construction of an aquarium, with police setting up a cordon at the demonstration site.

Fresh anti-Government protests have erupted in Iran as students held protests which led to clashes at several Iranian universities

An organized crime network operating fraudulent call centers in Dnipro, Ukraine, has been dismantled, leading to the arrest of 11 individuals involved in investment fraud that also affected Latvian residents.
The Embassy of the Republic of Poland in Mexico issued a recommendation for all Polish citizens in connection with the killing of 59-year-old Nemesio Oseguera Cervantes, the head of the cartel known as "E

Numerous citizens in Montenegro have expressed dissatisfaction with their high January electricity bills, filing complaints with Elektroprivreda Crne Gore (EPCG). The majority of these complaints have been rejected as unfounded.

DEDDIE, the Hellenic Electricity Distribution Network Operator, is warning citizens about the dangers of flying kites, particularly the risk of electrocution and power outages if kites get tangled in power lines.
Nearly half of the students at Danish social and healthcare schools are over 35, opting for a three-year education with a trainee salary of over 26,000 kroner, which is well-received by citizens.

Central bank has about $45bn worth of bullion but wary citizens are sceptical about selling it
Several countries' embassies in Mexico have issued warnings to their citizens on Sunday, local time, regarding an unspecified situation.

The United States has advised its citizens in several regions of Mexico to shelter in place due to escalating violence following a Mexican military operation that resulted in the death of a cartel leader, 'El Mencho'.

The Trump administration is reportedly weighing a new order that would compel banks to collect information on individuals' citizenship status for account creation and maintenance.
The Trump administration is exploring new measures that would mandate banks to collect additional citizenship information from customers as part of its broader efforts to crack down on illegal immigration.

The US Central Intelligence Agency (CIA) has published instructions on its official X account, guiding Iranians on how to establish safe contact.

Reaffirming Nigeria’s constitutional commitment to religious freedom, the government noted that the Constitution guarantees freedom of religion and worship for all citizens. The post FG rebuts US Congress report, says no policy of religious persecution appeared first on Vanguard News.

The Director of the Agency for Spatial Planning and Urbanism announced that the deadline for correcting technical errors in property rights registration is March 10, and citizens have the right to object.
Dual British citizens need UK passports to travel there from today - but can try their luck with an expired passport if they have to.

The Slovak opposition party PS claims the coalition plans to significantly restrict voting rights for Slovaks abroad by abolishing mail-in voting, requiring citizens to vote at embassies instead, though the interior ministry denies preparing such a change.

Montenegro's SEP warns that demographic problems threaten the country, socio-economic challenges encourage emigration, and inflation is gradually leading citizens towards increasingly difficult material status and poverty.

In the initial round of Croatia's latest treasury bill subscription, more than 17,600 citizens invested over 606 million euros in 364-day treasury bills, contributing to the total issue amount which also includes institutional investor offers.

A new citizens' group called 'Bor Boranima' (Bor for the People of Bor) has been formed in Bor, Serbia, led by the sole opposition MP and city councilor from Bor, aiming to represent non-partisan opposition figures.

The Nikšić Health Center has acquired two new official vehicles, which are expected to improve the accessibility of health services for citizens, especially in suburban and rural areas, and enhance the safety of staff transport.
Starting February 25, British dual nationals, including British-Canadian citizens, will be required to present a British or Irish passport, certificate of entitlement, or emergency travel document to enter the U.K.
Saudi Arabia has initiated the registration process for Hajj 1447 AH (2026) for citizens and residents within the Kingdom via the Nusuk platform, prioritizing first-time pilgrims.

Prime Minister Pedro Sánchez has announced that the government will release a trove of classified documents about 23-F ‘to settle a debt with citizens.’ Questions remain about the role played by former king Juan Carlos I, about the support shown by the army, and the extent of civilian involvement

According to data from the Centre of Registers, citizens of Russia and Belarus collectively own approximately 12,700 real estate properties in Lithuania.
Reports indicate that 18 Senegalese citizens are being held in Morocco, with one individual, Ibrahima Barry, facing a 'double punishment'.

Deputy Klevis Balliu accuses the Albanian government of protecting Belinda Balluku from 11 accusations of tender violations totaling 1.1 billion euros, while citizens face arrests for protests.

An international law enforcement operation in Ukraine led to the arrest of 11 individuals involved in a sophisticated scheme to defraud unsuspecting citizens with promises of impressive profits.

Rana, 64, is a Pakistan-born Canadian national and close associate of one of the main conspirators of the 2008 Mumbai terror attacks, David Coleman Headley, alias Daood Gilani, a U.S. citizen
Taiwan confirms citizens in Mexico safe after cartel violence Taiwan News
The European Commission is seeking solutions to the growing shortage of professional drivers, as difficulties in legalizing the stay of non-EU citizens hinder the transport industry's operations.

Dr. Mrs. Beatrice Wiafe Addai, founder of Breast Care International (BCI), is advocating for an urgent ban on shisha smoking in Ghana, citing its alarming link to breast cancer among young citizens.

Canada is reportedly taking steps to revoke the citizenship of Tahawwur Rana, an individual linked to the 2008 Mumbai attacks, ahead of a high-profile visit by Mark Carney to India.

Ghana's Ministry of Energy and Green Transition has assured citizens that recent electricity disruptions in Accra and other regions are localized incidents and not part of a nationwide load-shedding exercise.
France is launching a campaign to encourage young people to freeze their eggs and sperm, including sending letters to all 29-year-old citizens to remind them about the biological clock.

Action will be taken against any Singaporean who fights overseas in foreign causes, Coordinating Minister for National Security K Shanmugam has said, emphasising the importance of racial and religious harmony in maintaining peace in Singapore. He also noted the critical role of religious and community leaders who help set the tone for harmony in Singapore. Shanmugam, who is also Minister for Home Affairs, was speaking at a fast-breaking session co-organised by Khadijah Mosque and the Religiou...

West Virginia state legislators have introduced a bill, authored by Gun Owners of America, that would authorize the sale of machine guns to American citizens within the state.
An article from China Daily highlights how the Communist Party of China's pragmatic approach to development is benefiting its citizens and leading to prosperity.

Concerns are being raised in the UK regarding data rights due to contracts awarded to the US tech giant Palantir by the NHS and Ministry of Defence.

The United States Department of State issued a security alert urging American citizens in certain areas in Mexico to shelter in place.

An article analyzes Cuba's 'two-speed economy,' where some citizens can afford luxuries while others struggle, highlighting the severe economic challenges faced by the island.

Finnish figure skaters Juho Pirinen and Yuka Orihara will compete in the World Championships, even after losing their Olympic spot due to Orihara's citizenship not being processed in time.

As global travel continues to grow in importance, understanding the types of passports available in Nigeria is essential for citizens who travel frequently or plan to travel abroad. The post 3 types of passports Nigerians can own and what they mean appeared first on Vanguard News.

The Municipality of Nikšić has paid out 71,000 euros in compensation since the beginning of the year, prompting questions about the management of the city's dog shelter and a recently established reserve. Citizens and authorities are weighing in on the budget expenditure.
Iraq took in the detainees in an operation arranged with the United States after Kurdish forces retreated and shut down camps and prisons that had housed IS suspects for nearly a decade.

The Portuguese Tax Authority (Fisco) is alerting citizens about fraudulent messages that prompt taxpayers to click links for undue payments, advising them to ignore such communications.
Russia has reportedly issued a “stop-list” to military recruiters, banning citizens from as many as 43 countries from enlisting to fight in Ukraine, according to the independent media outlet iStories.

The UK has introduced eVisas for Nigerian citizens, while the US is expanding short-term travel access for individuals in Ghana, reshaping international travel in West Africa.

Citizens from 75 countries are serving in the units of Ukraine's Ground Forces, participating in the defense against Russian aggression, as revealed by Kostiantin Milevskii, deputy head of the Department for coordination of military service.

In Ghana’s vibrant democracy, true leadership is about empowering citizens, not controlling them. It is about lifting people, not dragging them into hardship. Across generations, Ghanaian leaders have demonstrated that public service is an apprenticeship — mentoring minds, funding start-ups, and creating platforms for young voices to be heard.
US Warns Citizens To Shelter in Place After Mexico’s ‘El Mencho’ Raid Forbes

A daily news round-up from Sweden on February 23rd, 2026, covering topics such as criticism of citizenship policies, a fire in Stockholm, restrictions on immigrant benefits, and Team Sweden's record performance at the Winter Olympics.

Lithuanian border guards arrested two men, Romanian and Lithuanian citizens, wanted by Interpol under European arrest warrants at Kaunas Airport and Medininkai border crossing.
During the Visakhapatnam Metropolitan Region Development Authority's (VMRDA) 'Praja Darbar,' citizens raised concerns regarding the proposed Master Plan.
Despite Brexit, the British government is once again allowing EU citizens access to its educational institutions through the Erasmus program.
The Supreme Court has rejected a plea by Overseas Citizens of India (OCI) seeking parity with Non-Resident Indians (NRIs) in state bar council membership.

The Supreme Court faced criticism from President Donald Trump after striking his tariff agenda this week, as the president looks towards an upcoming ruling.

The final electoral roll for Tamil Nadu has been published, with instructions provided on how citizens can check their names and what to do if their names have been deleted.

Tensions are high in Dragostunjë, Albania, where dozens of residents and citizens are clashing with police after being prevented from passing through a road segment blocked by landslides.

The Ministry of Foreign Affairs has appealed to Macedonian citizens in Mexico to leave the country and recommended postponing all non-essential travel to the state.

Mexican President Claudia Sheinbaum urged citizens on Sunday to remain calm and stay informed following the operation that led to the death of narcotrafficking kingpin Nemesio Oseguera, one of the most-wanted criminals in the country. The post Photos: Mexican president calls for calm as violence erupts after drug lord’s killing appeared first on Vanguard News.
Greece's tax authority is tightening its measures to identify and tax undeclared income held by its citizens abroad.

Tvyrant nerimui dėl galimų JAV smūgių Teheranui, Indijos užsienio reikalų ministerija pirmadienį paragino savo piliečius palikti Iraną.

Official data indicates that Romanian citizens spent a total of EUR 10 billion on vacations abroad during the year 2025.
India issues safety alert; urges citizens to leave Iran 'by all means' Khaleej Times

Montenegro will have its first-ever representative at the Winter Paralympic Games in Milan and Cortina, with Milatović stating that Šibalić has already earned a gold medal from all citizens.

The Indian Embassy has issued an advisory urging its citizens to leave Iran by available means of transport, including commercial flights.

Irish citizens are being advised that they should not travel to parts of Mexico after one of the country's most notorious drug lords was killed in a military raid.
The Tunisian Ministry of Health has introduced a new digital application designed to streamline the process for citizens to submit complaints and inquiries regarding health services.

School was canceled in several Mexican states and local and foreign governments alike warned their citizens to stay inside following the army's killing of the leader of the Jalisco New Generation Cartel, Nemesio Rubén Oseguera Cervantes, "El Mencho," and the violence it spurred
The South Korean embassy in Iran has issued a warning, advising its citizens to immediately leave the country due to escalating tensions following statements by US President Donald Trump.
The Indian Embassy has issued an urgent shelter alert for its citizens in Mexico following an outbreak of cartel violence.
Buildings and vehicles were vandalised as hundreds of fires dotted the skyline of Mexico's Guadalajara after the army killed Nemesio Rubén Oseguera Cervantes or "El Mencho", the leader of the Jalisco New Generation Cartel.
Hundreds of thousands of Russian citizens are hiring themselves out as killers for money, and the rest of society is paying for it, so far without complaint.

LONDON: Thousands of dual British nationals risk being denied boarding on flights, ferries and trains to the United Kingdom from Feb 25, unless they carry a valid British passport as new border controls come into force this week. The change confirmed by the UK Home Office means British citizens who also hold another nationality will be required to present a British passport when travelling to the UK. Those without one must apply for a “certificate of entitlement” attached to their non-Britis...

As authorities in Mexico combat the narco gangs terrorizing Puerto Vallarta and other parts of the country, the citizens -- and pets -- are left running for cover. In a new video shared online, a dog

Konstantinos Kyranakis, the Alternate Minister of Infrastructure and Transport, announced the launch of the new digital platform railway.gov.gr. This platform will allow citizens to monitor real-time railway operations, aiming to change the culture within the Hellenic Railways Organization (OSE).

A 32-year-old BiH citizen has been remanded in custody on suspicion of causing the tragedy on the Una by smuggling Chinese citizens in an inadequate boat that capsized, killing one person.

The Montenegrin Government building was illuminated in the colors of the Ukrainian flag, symbolizing support and solidarity for Ukraine and its citizens.

Socrates Famelos, on behalf of SYRIZA-PS and progressive Greek citizens, expressed strong concern and solidarity with the Cuban people, calling them an example.

Actor Robert De Niro called on American citizens to resist Donald Trump and his administration, stating it is the only way to 'save the country'.

A citizens group has raised concerns and put the Pune civic body's footpath repair campaign under scanner.

The Home Office has confirmed that British citizens holding a second nationality risk being blocked from entering the UK from Wednesday, as the government ignores pleas for a grace period before new rules take effect.
Telangana has launched the Mee Seva digital ticketing app to provide seamless bus travel for its citizens, streamlining the public transportation experience.

Moldova, which received EU candidate status in 2022 and reaffirmed its European direction in last year's parliamentary elections, sees its citizens near the Romanian border aspiring for full EU membership.

The Romanian Ministry of Internal Affairs (MAI) has issued a warning about a dangerous fraud attempt involving a fake website cloning HotNews.ro, which is spreading a scam promising citizens 65,000 lei. HotNews.ro's publisher, ZYX Publishing Group, has reacted, clarifying they did not publish the fraudulent article.

Ilda Zhulali, head of the Democratic Party's Foreign Relations Department, commented on SPAK's investigation into Belinda Balluku, alleging 'giant corruption and life threats' and stating her continued tenure poses a risk to citizens.

A new Odoxa-Mascaret poll indicates that 55% of French citizens do not wish to re-elect their current mayors, a slight increase from 52% in June.

Croatian MP Boris Lalovac (SDP) highlighted that citizens' incomes drastically fall upon retirement and emphasized the need to change the existing pension model.

I. Bratakos stated that financing small and medium-sized enterprises (SMEs) is not merely social policy but a developmental necessity for a resilient economy, ensuring consistent businesses and citizens have access to resources.

The director of Podgorica's 'Vodovod' (Waterworks) denies claims by Botunjani regarding the excavation of 'dangerous, carcinogenic KAP waste,' assuring citizens and employees there is no risk.

An article advocates for a credible 2026 budget in South Africa that is not solely based on spreadsheets but rebalances power and investment towards local economies to sustain the majority of citizens.

A new poll by Interview indicates that New Democracy holds 31.6% in vote estimation, with a majority of citizens (53%) believing a third government term for the party is likely. Prime Minister Kyriakos Mitsotakis remains dominant in the political scene.

DPS MP Elvir Zvrko stated that while identities can be broad in the 21st century, Montenegro remains the common home, obligation, and line of defense for its citizens.

Two paper containers were set on fire in Zagreb, and citizens detained the suspect until police arrived.

Despite intensified police checks for fare evaders, certain categories of citizens are legally entitled to use public transport in Athens and Thessaloniki with reduced or no fare.
Most Swiss citizens living abroad are already accustomed to the concept of individual taxation, according to a recent report.

Hungarian Prime Minister Viktor Orbán, during a campaign stop, made questionable claims regarding the 'Friendship' pipeline, stating that Hungary should not be treated as naive or foolish, while seemingly treating his own citizens as such.
Analysts maintain a positive outlook for Citizens Financial (CFG), anticipating continued upside potential despite the company's strong year-to-date performance.

The Canadian government has reportedly started proceedings to revoke the citizenship of 26/11 Mumbai terror attack mastermind Tahawwur Hussain Rana.

Tahawwur Rana, who is also a key associate of fellow Mumbai attacks mastermind David Coleman Headley, was extradited in 2025 after a long legal battle.

“I am determined to rescue this country. And as long as we work together in delivering hope to our citizens, the best is yet to come for Nigeria.” The post Tinubu vows to establish state police to curb insecurity appeared first on Vanguard News.
A report explores the sentiments and opinions of Croatian citizens regarding foreign workers in the country.

The French foreign minister is set to summon the US ambassador for discussions regarding comments made about the killing of a right-wing activist and US sanctions imposed on two French citizens.
Immigration, Refugees and Citizenship Canada (IRCC) has updated its instructions to simplify the study permit process for international students enrolled in joint programs and advanced degree tracks.

Russia has compiled a list of countries whose citizens are no longer permitted to fight against Ukraine, focusing on states considered 'friendly' to Russia.
Kyiv is reportedly coordinating with Baghdad in an effort to prevent the recruitment of Iraqi citizens into the Russian army, according to the Ukrainian Ambassador.

Greenland's Prime Minister declined an offer from then-US President Trump to send a hospital boat, reminding him that Greenland already provides free healthcare to its citizens.

The eight-day search for 19-year-old Manuel Ametov, a young man with developmental disabilities, has ended tragically with the discovery of his body. Citizens had previously blocked streets to demand help and accountability from institutions.

The City Boy Movement has commenced distribution of fasting relief packages across the 36 states to support citizens during the holy seasons of Ramadan and Lent. The post Ramadan, Lent: Seyi Tinubu rolls out relief packages nationwide appeared first on Vanguard News.

Everything that has happened in the last year, and above all the mood of the citizens, indicates to me that we are in the final phase of the dictatorial regime, which is already ready for history, said the professor.
A recent survey conducted by Animalia found that 64% of Finnish citizens would ban fur farming. The survey included 18,000 respondents from 20 different countries.
The Canadian government has begun the process to revoke the citizenship of Tahawwur Rana, a Pakistan-born businessman currently facing trial in India for allegedly helping plan the 2008 Mumbai terror attacks that killed 166 people. Canadian authorities have clarified that the move is not linked to terrorism charges but to alleged misrepresentation in his citizenship application.

Ghana's Parliament is reviewing the constitution to potentially allow dual citizens to hold key public offices, a move that could redefine national identity and public service.

The National Agency of Public Health (ANSP) in Moldova is urging citizens to get vaccinated against measles, emphasizing it as the only effective way to prevent the disease and its severe complications, following 193 reported cases in 2025.

Founder of Breast Care International (BCI) and CEO of Peace and Love Hospitals, Dr. Mrs. Beatrice Wiafe Addai, is calling for an urgent ban on shisha smoking in Ghana, citing the alarming health risks it poses to young citizens.
Reports have emerged about an individual with Icelandic citizenship serving in the Israeli army, following data obtained by the NGO Hatzlacha under Israeli information laws.
Indonesia Ready to Evacuate Citizens in Iran Amid US Tension Tempo.co English
The UK government has reportedly made quiet updates to its passport rules concerning dual citizens.

Czech Prime Minister Andrej Babiš will not attend a Senate public hearing on Ukraine's security, European security, and state defense capabilities. He stated that his program focuses on the daily lives of Czech citizens and that he has already addressed the war and Ukraine in his agenda.

The use of special surveillance means against magistrates in Bulgaria has reportedly exceeded its original purpose of combating serious crime, becoming a mechanism to discipline 'inconvenient' individuals within the justice system, making judges the most monitored citizens.
Trump Complains He’ll Lose Birthright Citizenship Case—Continuing Rant Against Supreme Court Tariff Ruling Forbes
Iran has threatened a counter-attack even in the event of a 'limited' US strike, as Washington increases its military presence in the Gulf and several countries advise their citizens to leave Iran.
Donald Trump stated that a Supreme Court ruling against his proposed order to end birthright citizenship would benefit China, connecting the domestic legal issue to international relations.
Tensions have escalated following a Syrian army offensive, leading Kurdish forces to abandon prisons and some Islamic State terrorists to flee into Iraq. Turkey has pledged to repatriate its citizens linked to ISIS who were detained in Iraq after being transferred from Syrian prisons.

Latest rant comes days after high court struck down his ‘Liberation Day’ tariffs
Citizens of Botswana have been invited to submit entries for the prestigious Tusk Conservation Awards, recognizing efforts in wildlife conservation.
The United Kingdom is set to introduce e-visas for Bangladeshi citizens starting from Wednesday.
India tells citizens to leave Iran Gulf News
India has advised its citizens currently in Iran to leave the country using available transportation, including commercial flights, due to escalating regional tensions.
Sweden's Council on Legislation has criticized a government proposal to significantly tighten requirements for Swedish citizenship, set to be implemented on National Day.

An international law enforcement operation, involving authorities from Ukraine, Latvia, and Lithuania, has shut down fraudulent investment call centers in Dnipro, Ukraine, which defrauded citizens of over 160,000 euros monthly.

The Central Bank of Cyprus (CBC) has announced that it will survey citizens across the island on savings and investment issues ahead of a public dialogue event in March. The central bank said it is organising an event on March 26, 2026 titled Financial Literacy for Life – European Citizens’ Dialogue. The event will take […]

The Ministry of Foreign Affairs has urged Dutch citizens in several Mexican states to stay indoors as much as possible due to unrest that erupted after the Mexican army killed Nemesio Rub

Two Albanian citizens were each fined 1,500 euros in Ulcinj, Montenegro, and prohibited from driving in Montenegro for four months.
A former Citizens Coalition for Change (CCC) candidate has won a Chegutu ward election, running on a Zanu PF ticket.

As tensions surrounding the possibility of a US military attack on Iran escalate, an evacuation advisory has been issued to Koreans staying in Iran. The Embassy of the Republic of Korea in Iran posted a safety notice on its website on the 22nd, stating that the security situation in Iran could change rapidly, and urged Korean citizens to frequently check media reports and embassy safety guidelines and pay special attention to their personal safety. In the notice, the embassy stated, 'Recent media...'
Four years into its full-scale war in Ukraine, Russia is experiencing significant economic consequences, impacting its citizens and infrastructure.
Consumer sentiment in Slovakia reached its lowest point in three years in January, with citizens earning less and actively seeking discounts, despite an improving situation abroad.
Justices of the Peace (JPs) in Jamaica are being urged to maintain high standards of integrity in their roles, particularly concerning passport and citizenship applications.
Following a European Court of Human Rights ruling in Strasbourg, Judge Beata Morawiec emphasizes the importance of citizens defending themselves against unlawful actions by authorities, expressing hope for a future where constitutional standards are upheld.
Embassies of several countries in Mexico have, on Sunday, local time, issued warnings to their citizens due to the unrest in the country following the killing of a cartel leader.